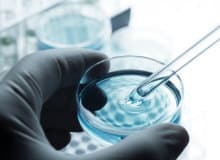

ABOUT
サービス概要
パートナーコンサルティングとは、包括契約で採用戦略や人材獲得を中長期的にサポートするサービスです。
企業戦略を実行する力のある人材を採用することで、経営者や事業責任者の想定よりも大きな成果を得られる場合があります。このサービスでは、貴社の事業戦略を踏まえて最適な採用計画を設計し、必要な人材の確保を支援させていただきます。

貴社の採用戦略を中長期的にトータルでサポート
- 採用の戦略面から実務までサポート
- 型にはまらない多様な採用手法を実施
- スポット契約より採用単価を抑えられる
CASE
サービスの利用例
某化学メーカー
中長期的な事業展開と研究開発を進める上で、優秀な人材の確保は不可欠ですが、従来の手法では採用が困難な状況でした。そこで弊社にご相談いただき、1~3年後を見据えた人材の獲得を目指して、年間を通じたフルサーチハンティングと指名ハンティングを併用。また、国外での現地人材採用では海外エージェントとのやりとりを代行するなど、採用活動全体をトータルにサポートしました。その結果、移籍人材の活躍により業績を順調に伸ばしております。
MERITS
パートナーコンサルティングのメリット
- 中長期にわたり採用の戦略から実務までサポート
- フルサーチハンティングの他、多様な採用手法を実施
- スポットでの契約と比較して採用単価が抑えられる
EFFECTIVE CASES
パートナーコンサルティングが効果的な要件
- 難易度の高いポジションを複数募集している
- 中長期的な事業戦略に基づいた採用計画がある
- 採用戦略や実務を外部パートナーと協業して進めたい
PRICE
費用
パートナーコンサルティングはご要望に応じたカスタマイズ対応となりますので、詳しくはお問い合わせください。


